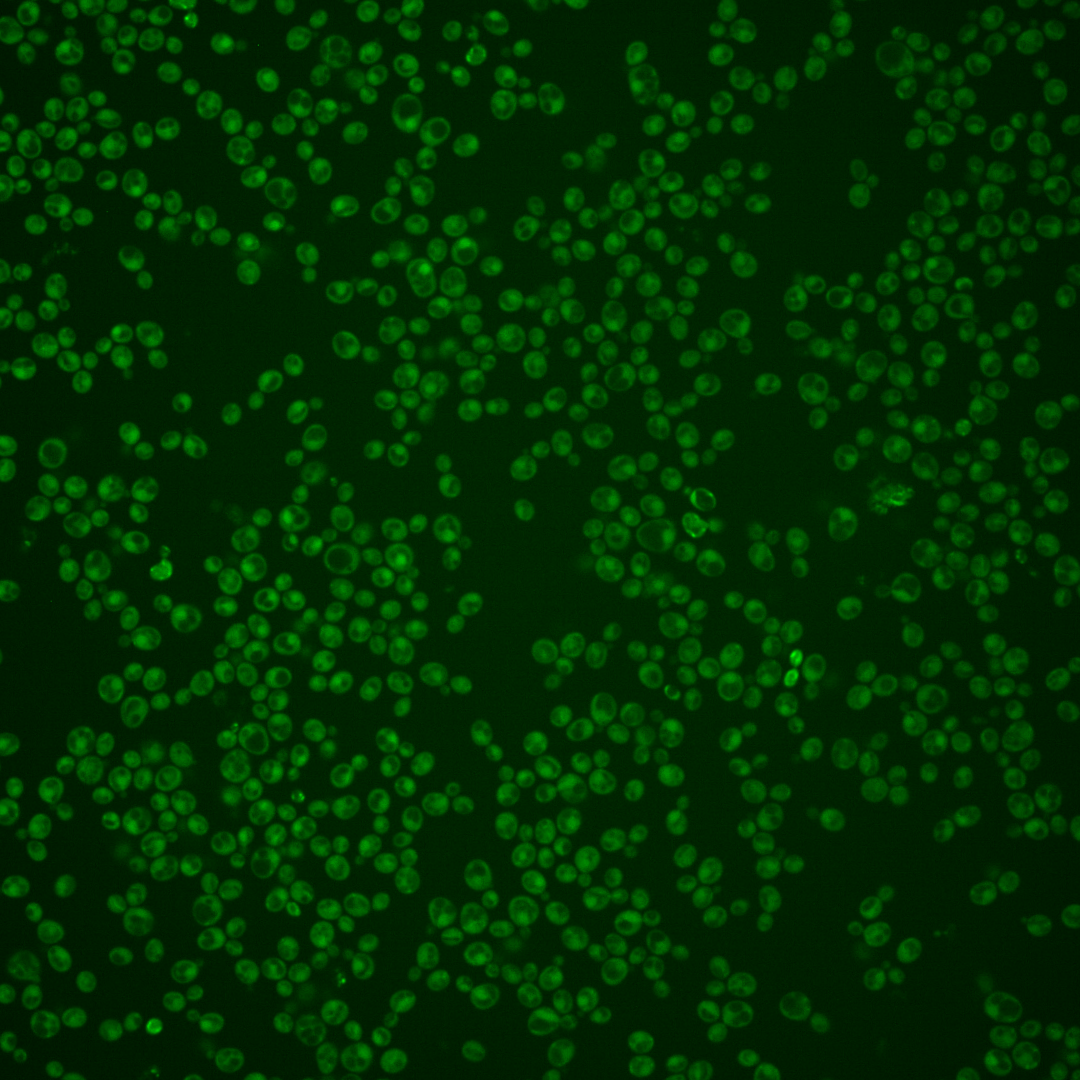
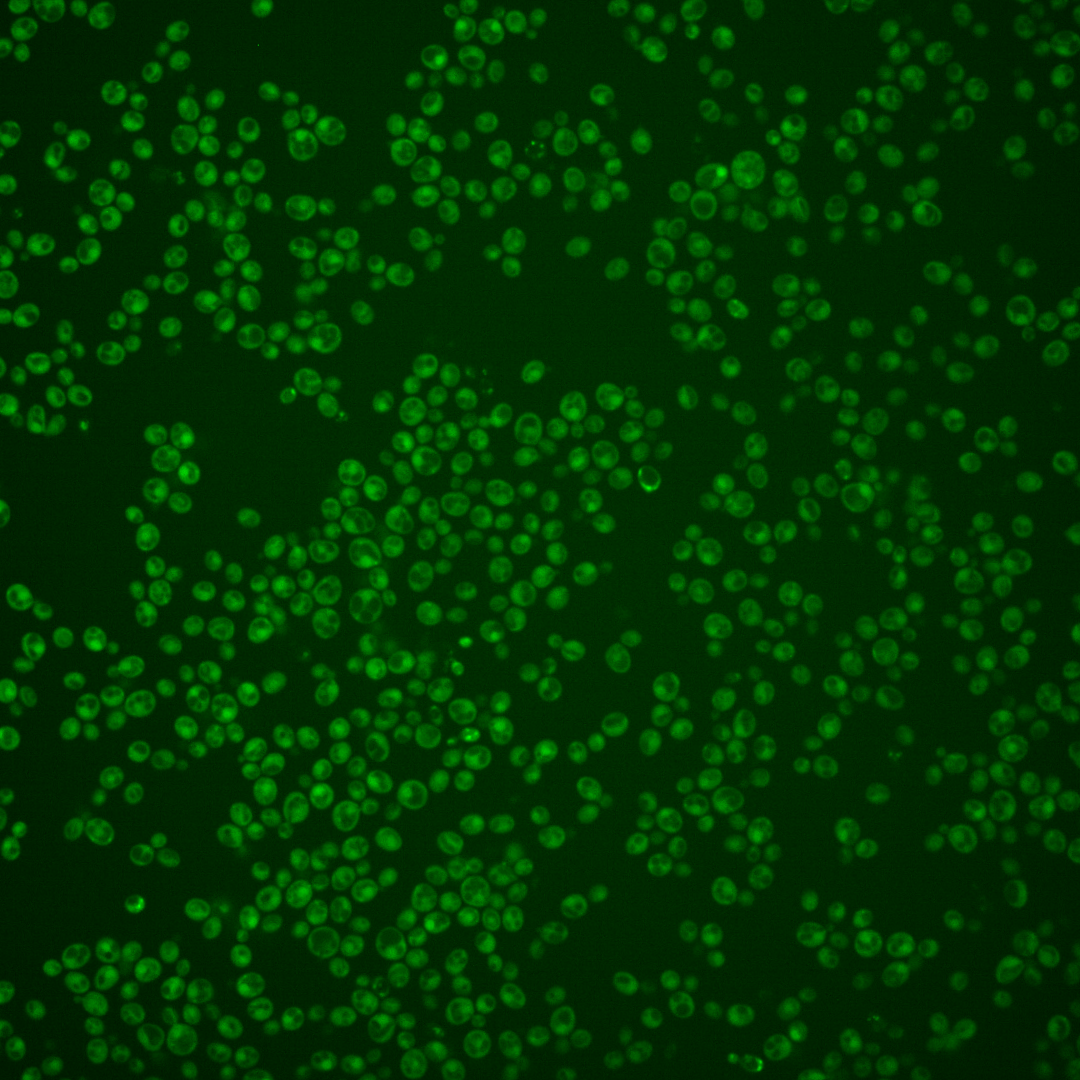
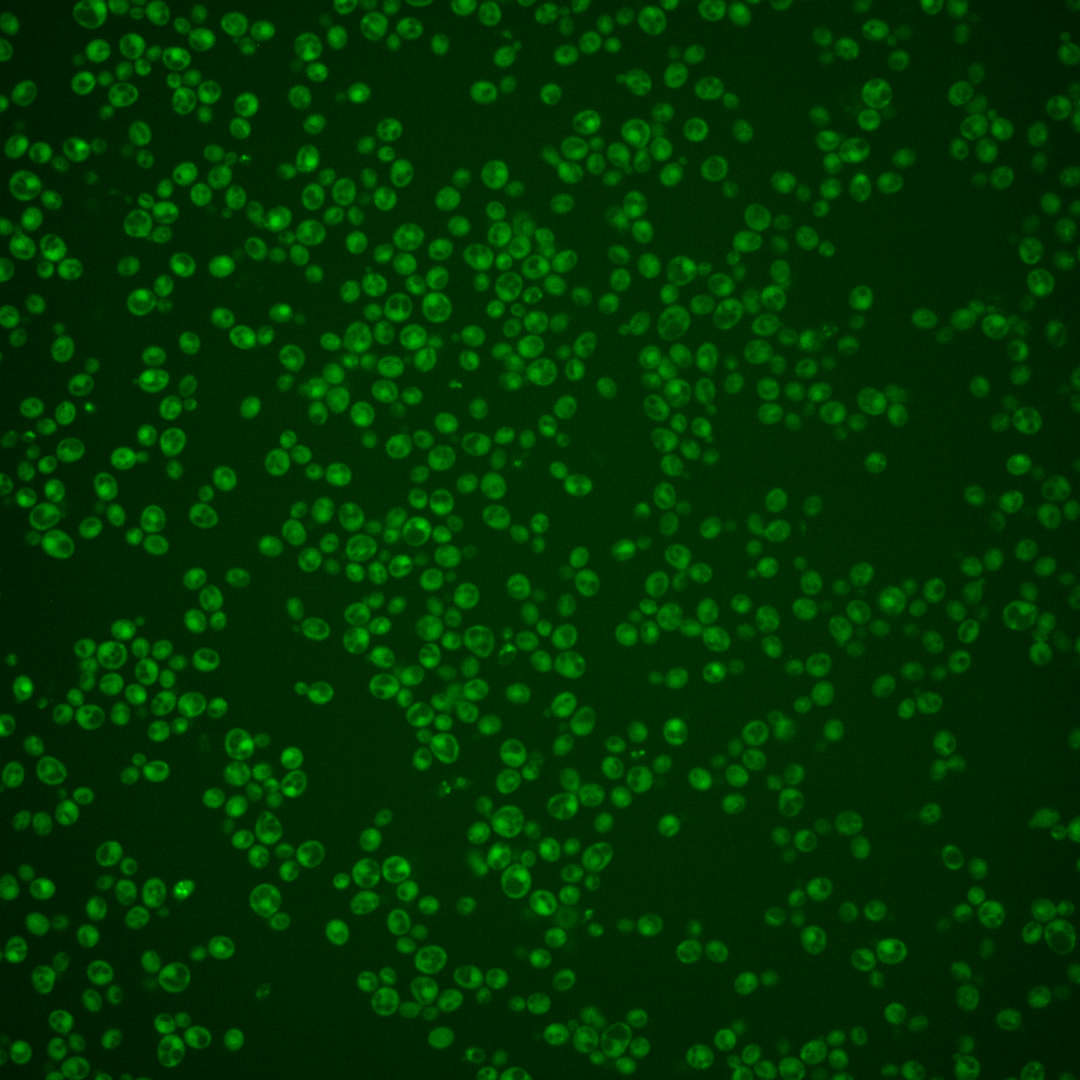
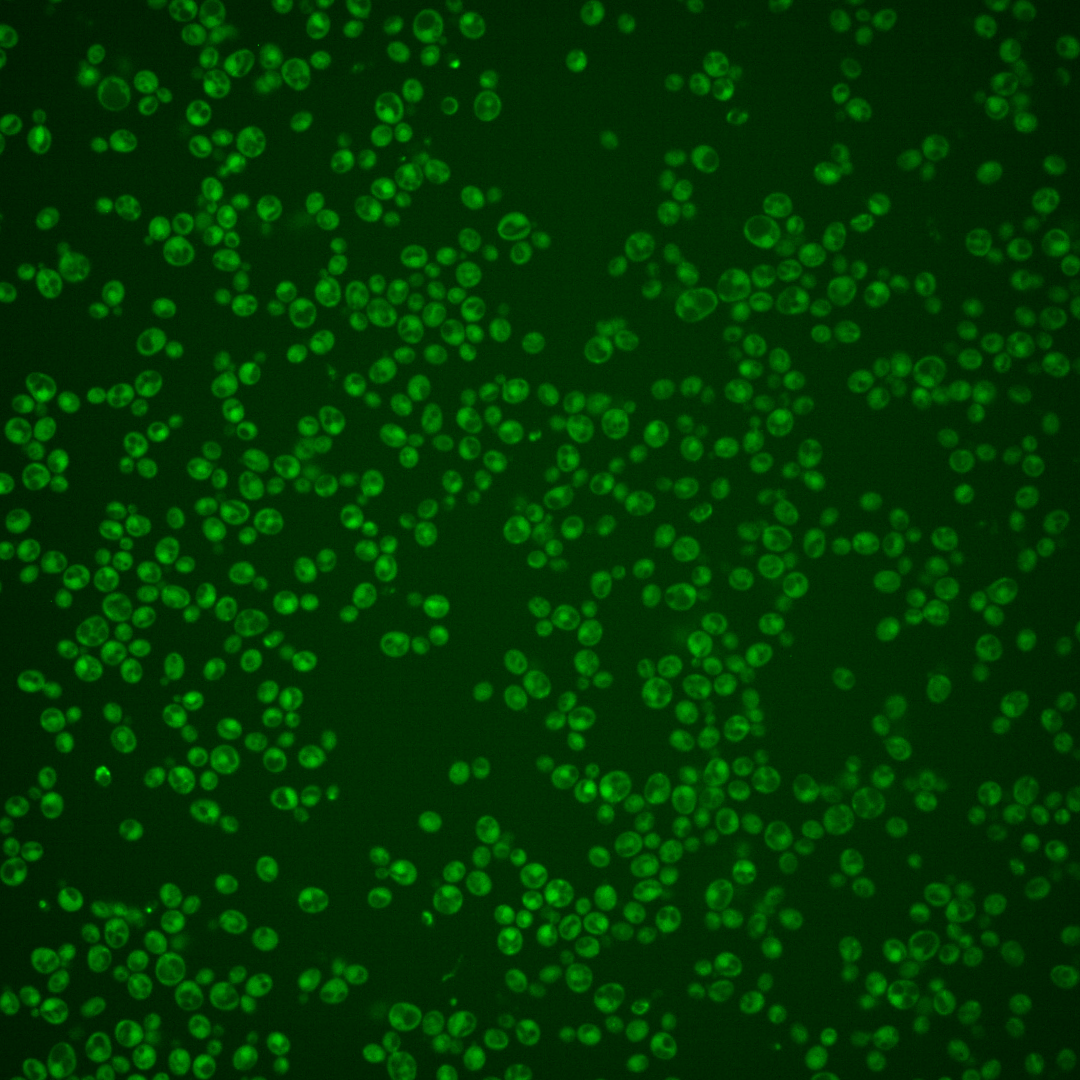
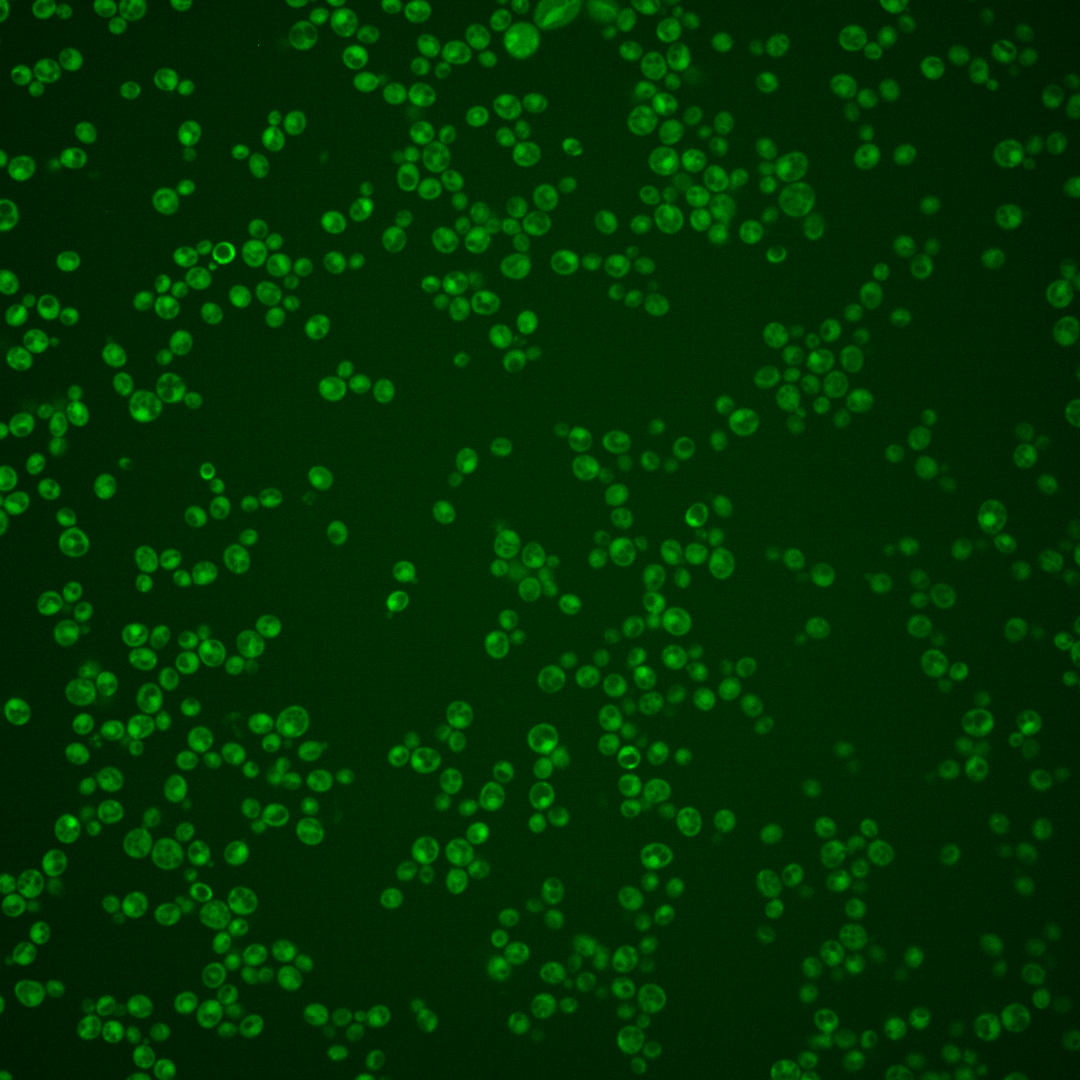
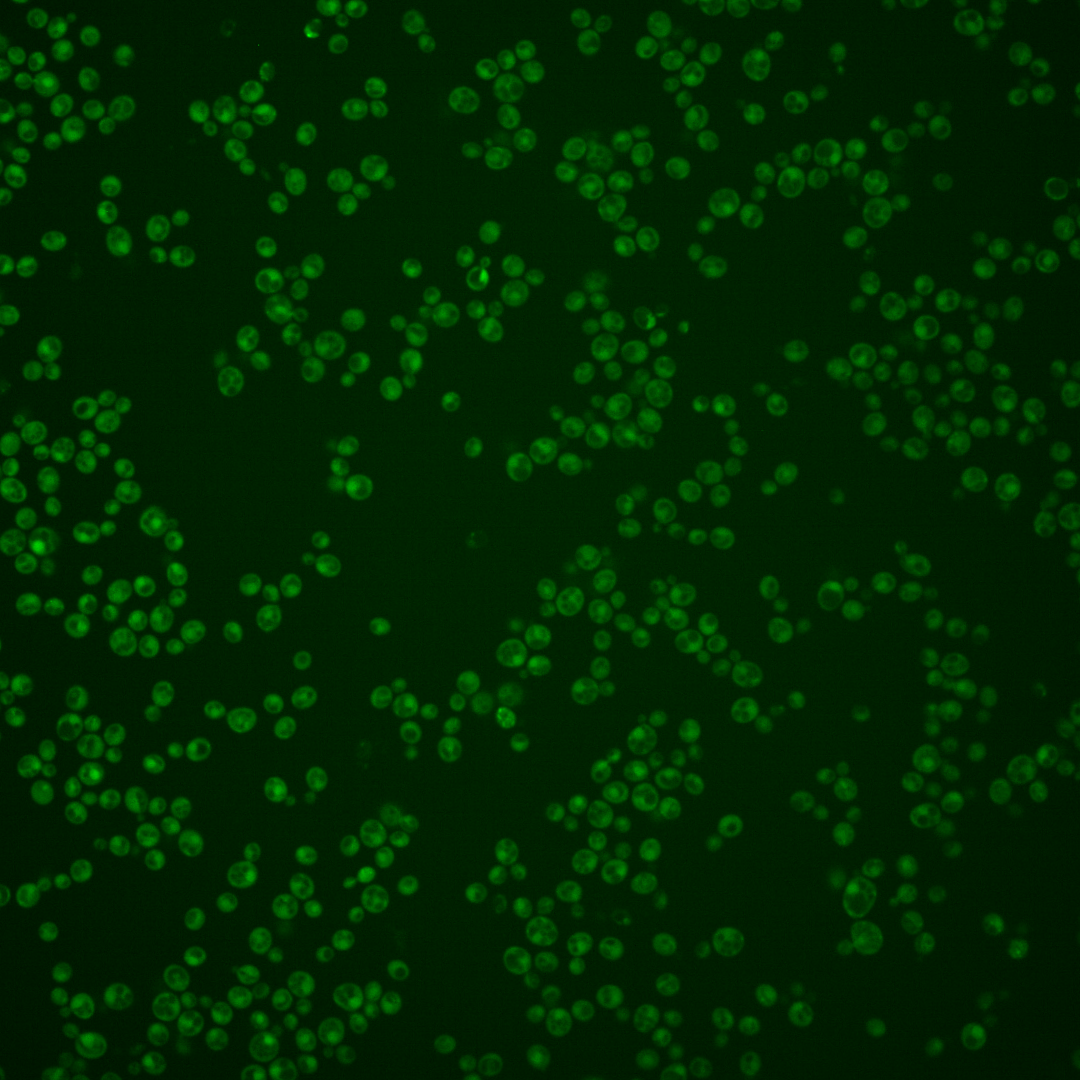
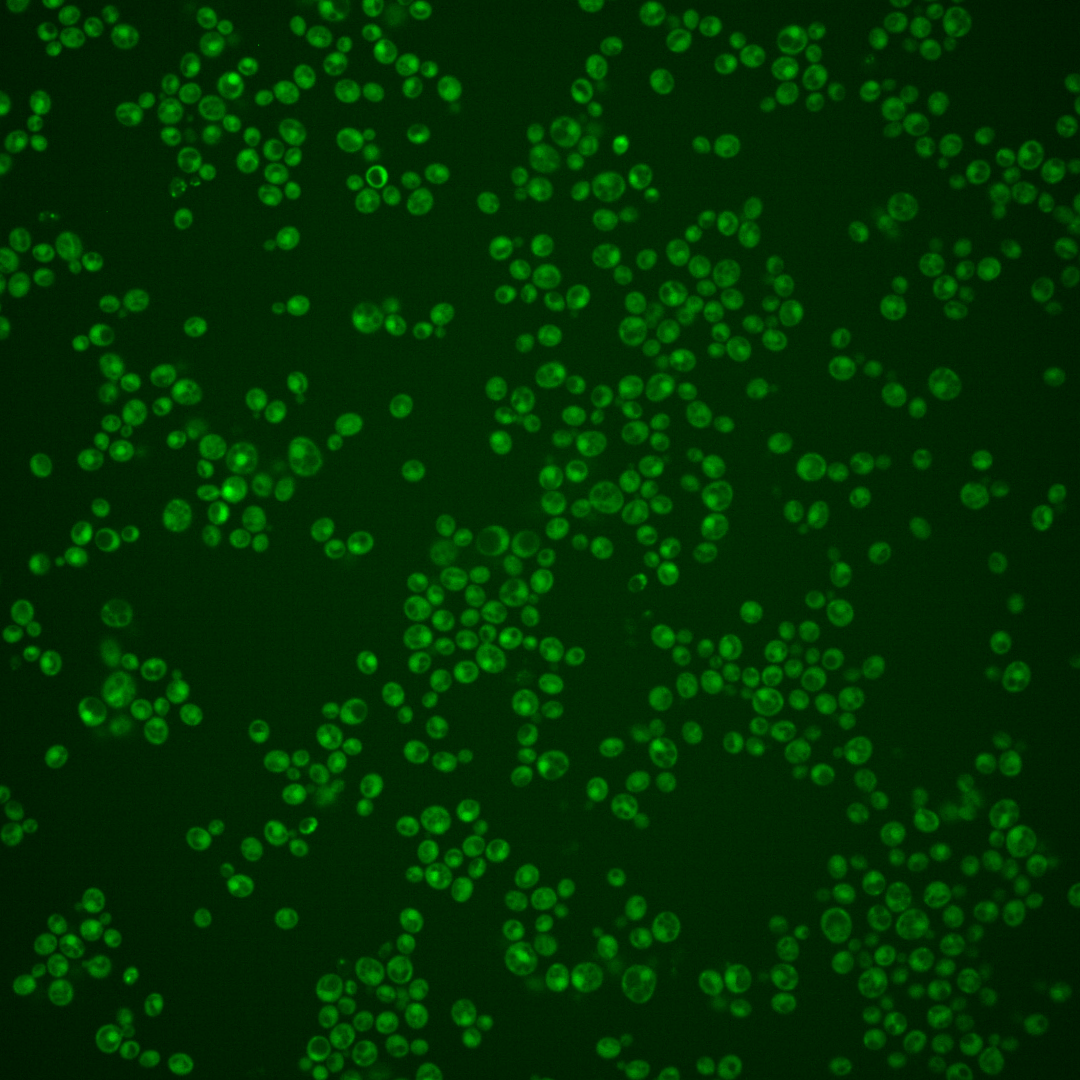
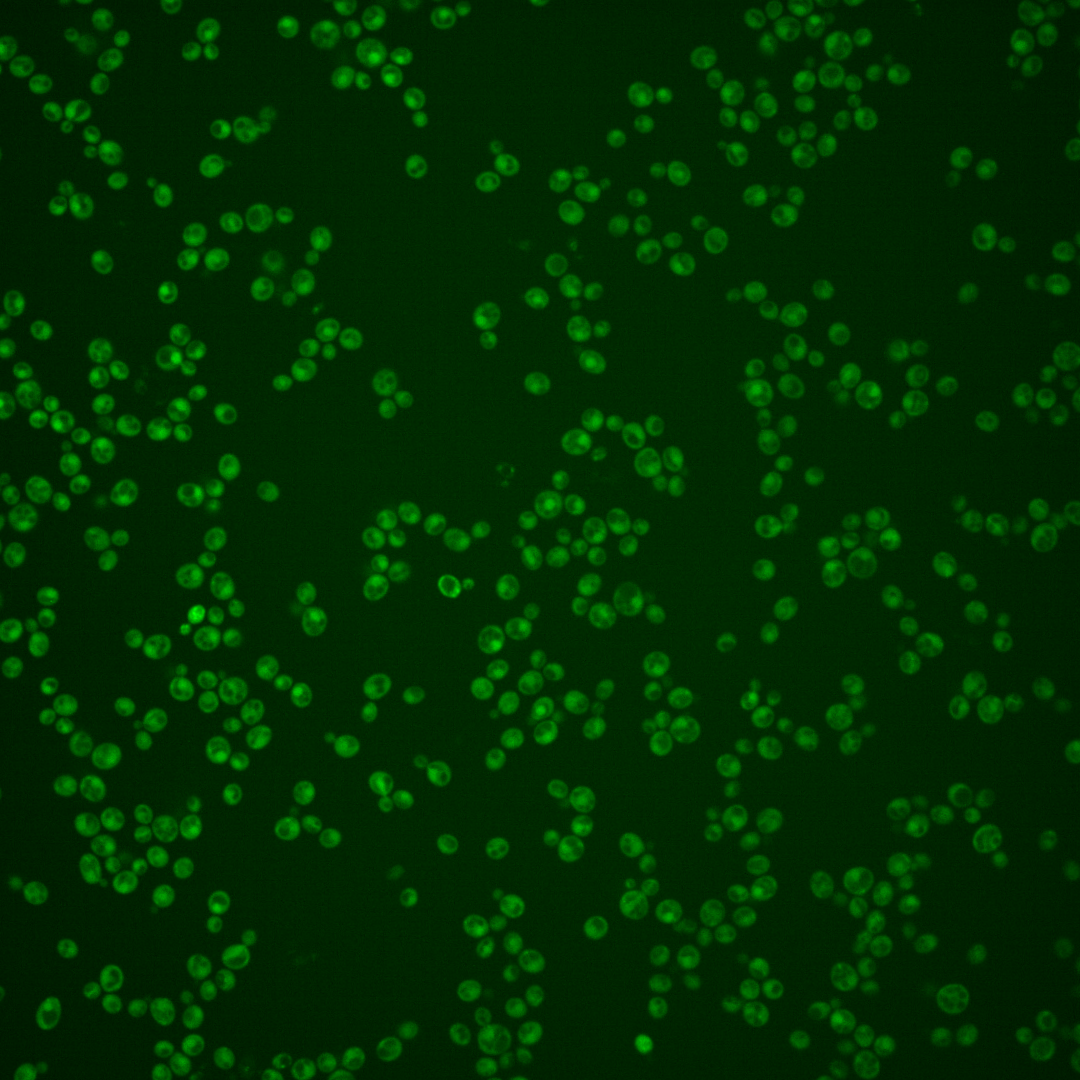

| Standard name | |
|---|---|
| Human Ortholog | |
| Description | Nuclear protein putative transcription factor; required for growth of superficial pseudohyphae (which do not invade the agar substrate) but not for invasive pseudohyphal growth; may act together with Phd1p; potential Cdc28p substrate |
Micrographs




















































































Sub-cellular Localization
Yeast GFP Assignment
Protein Abundance
Localization Change
External localization resources
| ensLOC | DeepLoc | |||||||||||||||||||||||
|---|---|---|---|---|---|---|---|---|---|---|---|---|---|---|---|---|---|---|---|---|---|---|---|---|
| Localization | WT1 | WT2 | WT3 | RAP60 | RAP140 | RAP220 | RAP300 | RAP380 | RAP460 | RAP540 | RAP620 | RAP700 | HU80 | HU120 | HU160 | rpd3Δ_1 | rpd3Δ_2 | rpd3Δ_3 | WT1 | WT2 | WT3 | AF100 | AF140 | AF180 |
| Cortical Patches | 0 | 1 | 0 | 0 | 0 | 0 | 0 | 0 | 0 | 0 | 0 | 0 | 0 | 0 | 0 | 0 | 0 | 0 | 2 | 0 | 1 | 1 | 1 | 2 |
| Bud | 0 | 0 | 0 | 0 | 0 | 1 | 1 | 5 | 4 | 5 | 0 | 6 | 0 | 0 | 0 | 0 | 0 | 1 | 1 | 0 | 0 | 0 | 4 | 3 |
| Bud Neck | 1 | 0 | 0 | 1 | 4 | 3 | 3 | 4 | 0 | 1 | 0 | 0 | 3 | 1 | 0 | 0 | 0 | 0 | 2 | 0 | 0 | 0 | 0 | 1 |
| Bud Site | 0 | 0 | 0 | 0 | 0 | 0 | 1 | 0 | 1 | 1 | 0 | 0 | 0 | 0 | 0 | 0 | 0 | 0 | – | – | – | – | – | – |
| Cell Periphery | 0 | 0 | 0 | 0 | 0 | 0 | 1 | 0 | 2 | 2 | 0 | 0 | 0 | 2 | 1 | 5 | 1 | 6 | 0 | 0 | 0 | 0 | 1 | 1 |
| Cytoplasm | 255 | 111 | 42 | 91 | 238 | 167 | 218 | 245 | 166 | 201 | 70 | 85 | 218 | 218 | 216 | 262 | 119 | 136 | 229 | 107 | 59 | 123 | 215 | 237 |
| Endoplasmic Reticulum | 4 | 0 | 0 | 0 | 0 | 0 | 0 | 0 | 0 | 0 | 0 | 1 | 2 | 0 | 0 | 7 | 6 | 5 | 0 | 0 | 0 | 0 | 1 | 2 |
| Endosome | 0 | 0 | 0 | 0 | 0 | 0 | 0 | 0 | 0 | 2 | 0 | 0 | 0 | 0 | 0 | 4 | 0 | 1 | 2 | 0 | 0 | 0 | 1 | 2 |
| Golgi | 1 | 0 | 0 | 0 | 1 | 0 | 0 | 0 | 0 | 1 | 0 | 0 | 0 | 1 | 1 | 1 | 1 | 0 | 1 | 0 | 0 | 0 | 1 | 0 |
| Mitochondria | 17 | 7 | 0 | 6 | 4 | 14 | 47 | 57 | 102 | 66 | 57 | 68 | 0 | 0 | 0 | 3 | 2 | 6 | 14 | 7 | 7 | 3 | 4 | 8 |
| Nucleus | 3 | 0 | 0 | 0 | 0 | 1 | 7 | 12 | 4 | 8 | 1 | 3 | 0 | 0 | 0 | 5 | 5 | 7 | 7 | 2 | 0 | 0 | 0 | 1 |
| Nuclear Periphery | 0 | 0 | 0 | 0 | 0 | 1 | 0 | 2 | 0 | 0 | 0 | 0 | 0 | 0 | 0 | 0 | 0 | 0 | 0 | 0 | 0 | 0 | 0 | 0 |
| Nucleolus | 0 | 0 | 0 | 1 | 0 | 0 | 0 | 0 | 0 | 2 | 1 | 1 | 0 | 0 | 0 | 0 | 0 | 1 | 0 | 0 | 0 | 0 | 0 | 0 |
| Peroxisomes | 0 | 0 | 0 | 0 | 0 | 0 | 0 | 0 | 0 | 0 | 0 | 0 | 0 | 0 | 0 | 0 | 0 | 0 | 1 | 0 | 0 | 0 | 0 | 0 |
| SpindlePole | 0 | 0 | 0 | 0 | 2 | 0 | 0 | 4 | 3 | 1 | 0 | 0 | 0 | 0 | 0 | 0 | 0 | 0 | 5 | 0 | 0 | 0 | 1 | 1 |
| Vac/Vac Membrane | 10 | 1 | 0 | 1 | 3 | 1 | 5 | 0 | 7 | 4 | 1 | 3 | 0 | 0 | 0 | 45 | 13 | 14 | 10 | 3 | 0 | 0 | 1 | 2 |
| Unique Cell Count | 279 | 116 | 42 | 94 | 245 | 175 | 248 | 282 | 229 | 246 | 102 | 135 | 220 | 219 | 217 | 303 | 139 | 157 | 289 | 124 | 73 | 134 | 245 | 270 |
| Labelled Cell Count | 291 | 120 | 42 | 100 | 252 | 188 | 283 | 329 | 289 | 294 | 130 | 167 | 223 | 222 | 218 | 332 | 147 | 177 | 289 | 124 | 73 | 134 | 245 | 270 |
Yeast GFP Assignment
Protein Abundance
| Screen | WT1 | WT2 | WT3 | RAP60 | RAP140 | RAP220 | RAP300 | RAP380 | RAP460 | RAP540 | RAP620 | RAP700 | HU80 | HU120 | HU160 | rpd3Δ_1 | rpd3Δ_2 | rpd3Δ_3 | AF100 | AF140 | AF180 |
|---|---|---|---|---|---|---|---|---|---|---|---|---|---|---|---|---|---|---|---|---|---|
| Mean Cell GFP Intensity (1e-4) | 3.4 | 3.7 | 4.4 | 4.1 | 4.7 | 4.1 | 3.9 | 4.2 | 3.4 | 4.0 | 3.5 | 3.7 | 4.7 | 4.8 | 4.9 | 6.3 | 6.6 | 6.5 | 4.1 | 4.8 | 4.9 |
| Std Deviation (1e-4) | 0.6 | 0.5 | 0.8 | 1.5 | 1.9 | 2.5 | 2.0 | 1.4 | 1.3 | 1.7 | 1.6 | 1.0 | 0.8 | 1.1 | 1.3 | 1.2 | 1.3 | 1.4 | 0.9 | 1.7 | 1.6 |
| Intensity Change (Log2) | – | – | – | -0.09 | 0.11 | -0.08 | -0.16 | -0.08 | -0.35 | -0.13 | -0.31 | -0.26 | 0.11 | 0.15 | 0.16 | 0.53 | 0.59 | 0.57 | -0.09 | 0.14 | 0.17 |
Localization Change
| Localization | RAP60 | RAP140 | RAP220 | RAP300 | RAP380 | RAP460 | RAP540 | RAP620 | RAP700 | HU80 | HU120 | HU160 | rpd3Δ_1 | rpd3Δ_2 | rpd3Δ_3 |
|---|---|---|---|---|---|---|---|---|---|---|---|---|---|---|---|
| Actin | – | – | – | – | – | – | – | – | – | – | – | – | – | – | – |
| Bud | – | – | – | – | – | – | – | – | – | – | – | – | 0 | – | – |
| Bud Neck | – | – | – | – | – | – | – | – | – | – | – | – | 0 | – | – |
| Bud Site | – | – | – | – | – | – | – | – | – | – | – | – | 0 | – | – |
| Cell Periphery | – | – | – | – | – | – | – | – | – | – | – | – | 0 | – | – |
| Cyto | – | – | – | – | – | – | – | – | – | – | – | – | – | – | – |
| Endoplasmic Reticulum | – | – | – | – | – | – | – | – | – | – | – | – | 0 | – | – |
| Endosome | – | – | – | – | – | – | – | – | – | – | – | – | 0 | – | – |
| Golgi | – | – | – | – | – | – | – | – | – | – | – | – | 0 | – | – |
| Mitochondria | – | – | – | – | – | – | – | – | – | – | – | – | 0 | – | – |
| Nuclear Periphery | – | – | – | – | – | – | – | – | – | – | – | – | 0 | – | – |
| Nuc | – | – | – | – | – | – | – | – | – | – | – | – | – | – | – |
| Nucleolus | – | – | – | – | – | – | – | – | – | – | – | – | 0 | – | – |
| Peroxisomes | – | – | – | – | – | – | – | – | – | – | – | – | 0 | – | – |
| SpindlePole | – | – | – | – | – | – | – | – | – | – | – | – | 0 | – | – |
| Vac | – | – | – | – | – | – | – | – | – | – | – | – | – | – | – |
| Cortical Patches | – | – | – | – | – | – | – | – | – | – | – | – | 0 | – | – |
| Cytoplasm | – | – | – | – | – | – | – | – | – | – | – | – | 0 | – | – |
| Nucleus | – | – | – | – | – | – | – | – | – | – | – | – | 0 | – | – |
| Vacuole | – | – | – | – | – | – | – | – | – | – | – | – | 2.7 | – | – |
External localization resources
Images






























Protein Concentration and Protein Localization Data
| R1 | R2 | R3 | ||||||||||||||||
|---|---|---|---|---|---|---|---|---|---|---|---|---|---|---|---|---|---|---|
| G1 Pre-START | G1 Post-START | S/G2 | Metaphase | Anaphase | Telophase | G1 Pre-START | G1 Post-START | S/G2 | Metaphase | Anaphase | Telophase | G1 Pre-START | G1 Post-START | S/G2 | Metaphase | Anaphase | Telophase | |
| Concentration | 0.7993 | 1.4865 | 1.1804 | 1.0469 | 1.3557 | 1.2872 | -0.4487 | 0.4047 | -0.0104 | 0.6969 | 0.3341 | 0.2897 | -1.1063 | -0.7274 | -1.0622 | -0.1894 | -1.0485 | -0.6111 |
| Actin | 0.0161 | 0.0001 | 0.0108 | 0.0146 | 0.0415 | 0.0024 | 0.0123 | 0.0005 | 0.0004 | 0.0019 | 0.0086 | 0.0044 | 0.0216 | 0.0006 | 0.0062 | 0.0387 | 0.002 | 0.0119 |
| Bud | 0.0007 | 0.0003 | 0.0032 | 0.0009 | 0.0007 | 0.0019 | 0.0005 | 0.0024 | 0.0003 | 0.0068 | 0.0004 | 0.0004 | 0.0005 | 0.0001 | 0.0002 | 0.0012 | 0 | 0.0003 |
| Bud Neck | 0.0044 | 0.0004 | 0.0021 | 0.0058 | 0.001 | 0.001 | 0.0025 | 0.001 | 0.0004 | 0.003 | 0.0016 | 0.0031 | 0.0108 | 0.0002 | 0.0002 | 0.0009 | 0.0002 | 0.0012 |
| Bud Periphery | 0.0012 | 0.0002 | 0.0041 | 0.0012 | 0.001 | 0.0056 | 0.0005 | 0.0017 | 0.0002 | 0.0048 | 0.0008 | 0.0005 | 0.0008 | 0.0001 | 0.0004 | 0.0012 | 0 | 0.0003 |
| Bud Site | 0.0035 | 0.0129 | 0.0066 | 0.0086 | 0.0011 | 0.0004 | 0.0021 | 0.0242 | 0.001 | 0.0157 | 0.0024 | 0.0004 | 0.0063 | 0.0013 | 0.0008 | 0.007 | 0.0001 | 0.0011 |
| Cell Periphery | 0.0003 | 0.0001 | 0.0002 | 0.0002 | 0.0001 | 0.0001 | 0.0002 | 0.0003 | 0.0001 | 0.0005 | 0.0002 | 0 | 0.0005 | 0.0002 | 0.0001 | 0.0002 | 0 | 0.0001 |
| Cytoplasm | 0.2348 | 0.2848 | 0.2292 | 0.344 | 0.2079 | 0.3727 | 0.2611 | 0.2272 | 0.3216 | 0.2452 | 0.209 | 0.4635 | 0.3214 | 0.3925 | 0.4184 | 0.415 | 0.2037 | 0.556 |
| Cytoplasmic Foci | 0.0129 | 0.0041 | 0.0144 | 0.0105 | 0.012 | 0.0081 | 0.021 | 0.006 | 0.0104 | 0.0053 | 0.0219 | 0.0153 | 0.0216 | 0.0058 | 0.0085 | 0.0272 | 0.0138 | 0.0182 |
| Eisosomes | 0.0004 | 0.0001 | 0.0002 | 0.0001 | 0.0002 | 0.0001 | 0.001 | 0.0001 | 0.0001 | 0.0002 | 0.0004 | 0 | 0.0002 | 0.0001 | 0.0002 | 0.0003 | 0.0001 | 0.0001 |
| Endoplasmic Reticulum | 0.0025 | 0.002 | 0.0025 | 0.0032 | 0.0015 | 0.0013 | 0.0037 | 0.0012 | 0.0019 | 0.0011 | 0.0033 | 0.0014 | 0.0064 | 0.0022 | 0.0039 | 0.0057 | 0.0033 | 0.0041 |
| Endosome | 0.007 | 0.0013 | 0.0167 | 0.0142 | 0.032 | 0.0032 | 0.0135 | 0.0011 | 0.0028 | 0.0022 | 0.0206 | 0.0034 | 0.0083 | 0.0018 | 0.0054 | 0.0134 | 0.006 | 0.0193 |
| Golgi | 0.0029 | 0.0001 | 0.0019 | 0.0035 | 0.002 | 0.0011 | 0.0026 | 0.0001 | 0.0002 | 0.0005 | 0.0082 | 0.0002 | 0.004 | 0.0003 | 0.0018 | 0.0102 | 0.0004 | 0.0108 |
| Lipid Particles | 0.0035 | 0.0001 | 0.0018 | 0.0013 | 0.0041 | 0.0003 | 0.0039 | 0.0001 | 0.0006 | 0.001 | 0.0134 | 0.0003 | 0.0049 | 0.0004 | 0.0035 | 0.0068 | 0.001 | 0.0053 |
| Mitochondria | 0.0109 | 0.0002 | 0.0054 | 0.0339 | 0.0018 | 0.0011 | 0.0012 | 0.0004 | 0.0006 | 0.0008 | 0.0122 | 0.0004 | 0.0022 | 0.0001 | 0.0119 | 0.0133 | 0.0005 | 0.0035 |
| None | 0.6758 | 0.6423 | 0.6375 | 0.3172 | 0.3508 | 0.5555 | 0.6454 | 0.6622 | 0.5497 | 0.5028 | 0.2805 | 0.4476 | 0.5666 | 0.5792 | 0.4702 | 0.2212 | 0.3983 | 0.2916 |
| Nuclear Periphery | 0.0037 | 0.002 | 0.0056 | 0.0091 | 0.0065 | 0.0017 | 0.0044 | 0.001 | 0.0035 | 0.0062 | 0.0256 | 0.0017 | 0.0076 | 0.0011 | 0.0027 | 0.012 | 0.0048 | 0.004 |
| Nucleolus | 0.0007 | 0.0004 | 0.0009 | 0.0011 | 0.0041 | 0.0004 | 0.0007 | 0.0015 | 0.0007 | 0.0048 | 0.0041 | 0.0005 | 0.0003 | 0.0002 | 0.0004 | 0.0009 | 0.001 | 0.0006 |
| Nucleus | 0.0061 | 0.0454 | 0.0378 | 0.1959 | 0.2791 | 0.0328 | 0.0101 | 0.0519 | 0.0938 | 0.1749 | 0.3437 | 0.0428 | 0.0045 | 0.0111 | 0.0504 | 0.1904 | 0.3529 | 0.0526 |
| Peroxisomes | 0.0073 | 0.0001 | 0.0083 | 0.0017 | 0.0045 | 0.0032 | 0.0022 | 0.0001 | 0.0006 | 0.0008 | 0.0096 | 0.0005 | 0.0051 | 0.0001 | 0.0049 | 0.0199 | 0.0007 | 0.0083 |
| Punctate Nuclear | 0.0032 | 0.0024 | 0.0059 | 0.0313 | 0.0357 | 0.0063 | 0.0079 | 0.015 | 0.0098 | 0.0204 | 0.0271 | 0.0127 | 0.0019 | 0.0018 | 0.0075 | 0.0106 | 0.0099 | 0.0088 |
| Vacuole | 0.0019 | 0.0007 | 0.0043 | 0.0012 | 0.0111 | 0.0007 | 0.0027 | 0.0017 | 0.0009 | 0.0009 | 0.003 | 0.0007 | 0.0033 | 0.001 | 0.0015 | 0.0032 | 0.0009 | 0.0016 |
| Vacuole Periphery | 0.0004 | 0.0001 | 0.0009 | 0.0004 | 0.0012 | 0.0002 | 0.0007 | 0.0002 | 0.0002 | 0.0002 | 0.0034 | 0.0001 | 0.0012 | 0.0001 | 0.0008 | 0.0007 | 0.0002 | 0.0005 |
Sequencing Data
| R1 | R2 | |||||||||
|---|---|---|---|---|---|---|---|---|---|---|
| G1 Post-START | S/G2 | Metaphase | Anaphase | Telophase | G1 Post-START | S/G2 | Metaphase | Anaphase | Telophase | |
| Gene Expression | 5.8297 | 70.117 | 63.2796 | 52.4224 | 37.7923 | 4.2374 | 67.0631 | 91.1727 | 54.5108 | 30.9373 |
| Translational Efficiency | 0.8959 | 0.7607 | 1.0512 | 0.8034 | 0.6234 | 1.0319 | 0.9354 | 0.8767 | 1.0528 | 0.9012 |
Hit Data
| Dataset | Hit |
|---|---|
| Protein Concentration | ✔ |
| Protein Localization | ✘ |
| Gene Expression | ✔ |
| Translational Efficiency | ✘ |
Endocytosis
| Temp | Actin Patch (Sac6-tdTomato) | Cortical Patch (Sla1-GFP) | Late Endosome (Snf7-GFP) | Vacuole (Vph1-GFP) |
|---|---|---|---|---|
| 37℃ | ||||
| RT |
Cell Cycle Omics
CYCLoPs (Sfg1-GFP)
| Gene / Allele | Actin Patch (Sac6-tdTomato) | Cortical Patch (Sla1-GFP) | Late Endosome (Snf7-GFP) | Vacuole (Sac6-tdTomato) |
|---|
| Gene | Images |
|---|
| Gene | Images |
|---|
Images are not yet available
Images are not yet available